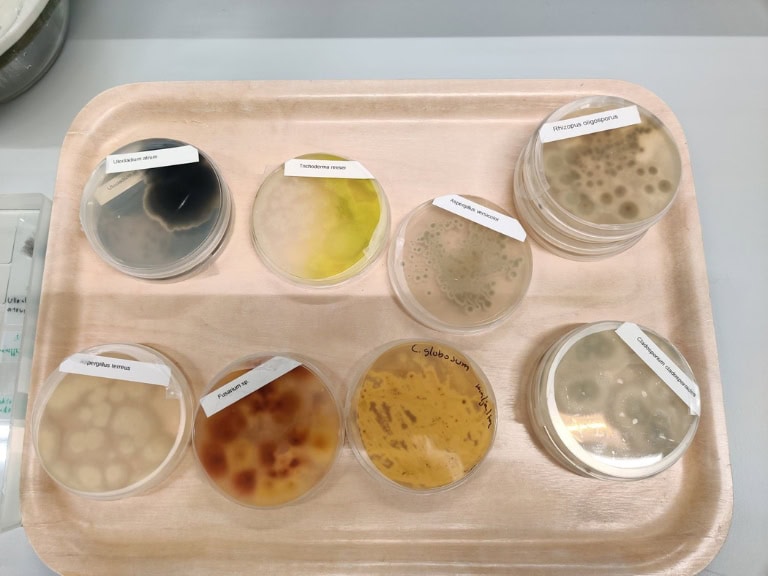

Sisäilman hometutkimus
Epäiletkö home- tai kosteusvaurioita? Home- eli mikrobitutkimus on helppo tapa selvittää onko sisäilmassa homeeseen viittaavia mikrobeja.

Mitä hometutkimus sisältää?
Näin hometutkimus etenee:

Mitä hometutkimus maksaa? Katso hinta
Sisäilman hometutkimus on edullisinta tehdä talvella, kun maa on jäässä ja lumen peitossa. Jos tutkimus tehdään muina aikoina (esim. keväällä, kesällä tai syksyllä), tulee ulkoilmasta ottaa vertailunäyte, johon sisäilman homepitoisuutta verrataan.
Talvella (maa jäässä)
690€ (sis. alv.)
Muut vuodenajat
990€ (sis. alv.)
Milloin tilata hometutkimus? Tunnista merkit!
Tunkkainen haju ja sisäilma
Maakellarimainen, ummehtunut tai pistävä haju voi viitata mikrobikasvuun rakenteissa. Hometutkimus selvittää, onko sisäilman ongelmien taustalla kosteusvaurio.
Värimuutokset ja homepilkut
Tummumat, kosteusjäljet ja homepilkut kertovat usein kosteuden pääsystä rakenteisiin. Mikrobitutkimus osoittaa, onko kyse pintavauriosta vai laajemmasta ongelmasta.
Terveydelliset oireet
Silmien, ihon tai hengitysteiden ärsytys, päänsärky ja väsymys voivat johtua sisäilman mikrobeista. Hometutkimus tuo varmuuden ja auttaa ehkäisemään pitkäaikaisia haittoja.

Haussa osaava hometarkastaja? Täältä löytyy!
Me Taykalla olemme täysin riippumaton rakennusten asiantuntijapalvelu, jolla on vuosien kokemus hometutkimuksista. Meiltä saat aina rehellistä palvelua, selkokielisiä vastauksia ja järkevät ehdotukset ongelmien korjaamisesta.
Pätevyyksiämme:
- Rakennusterveysasiantuntija (RTA)
- Sisäilma-asiantuntija (SISA)
- Kosteusvaurion kuntotutkija (KVKT)
- Kosteusvaurion korjaussuunnittelija (KVKS)
